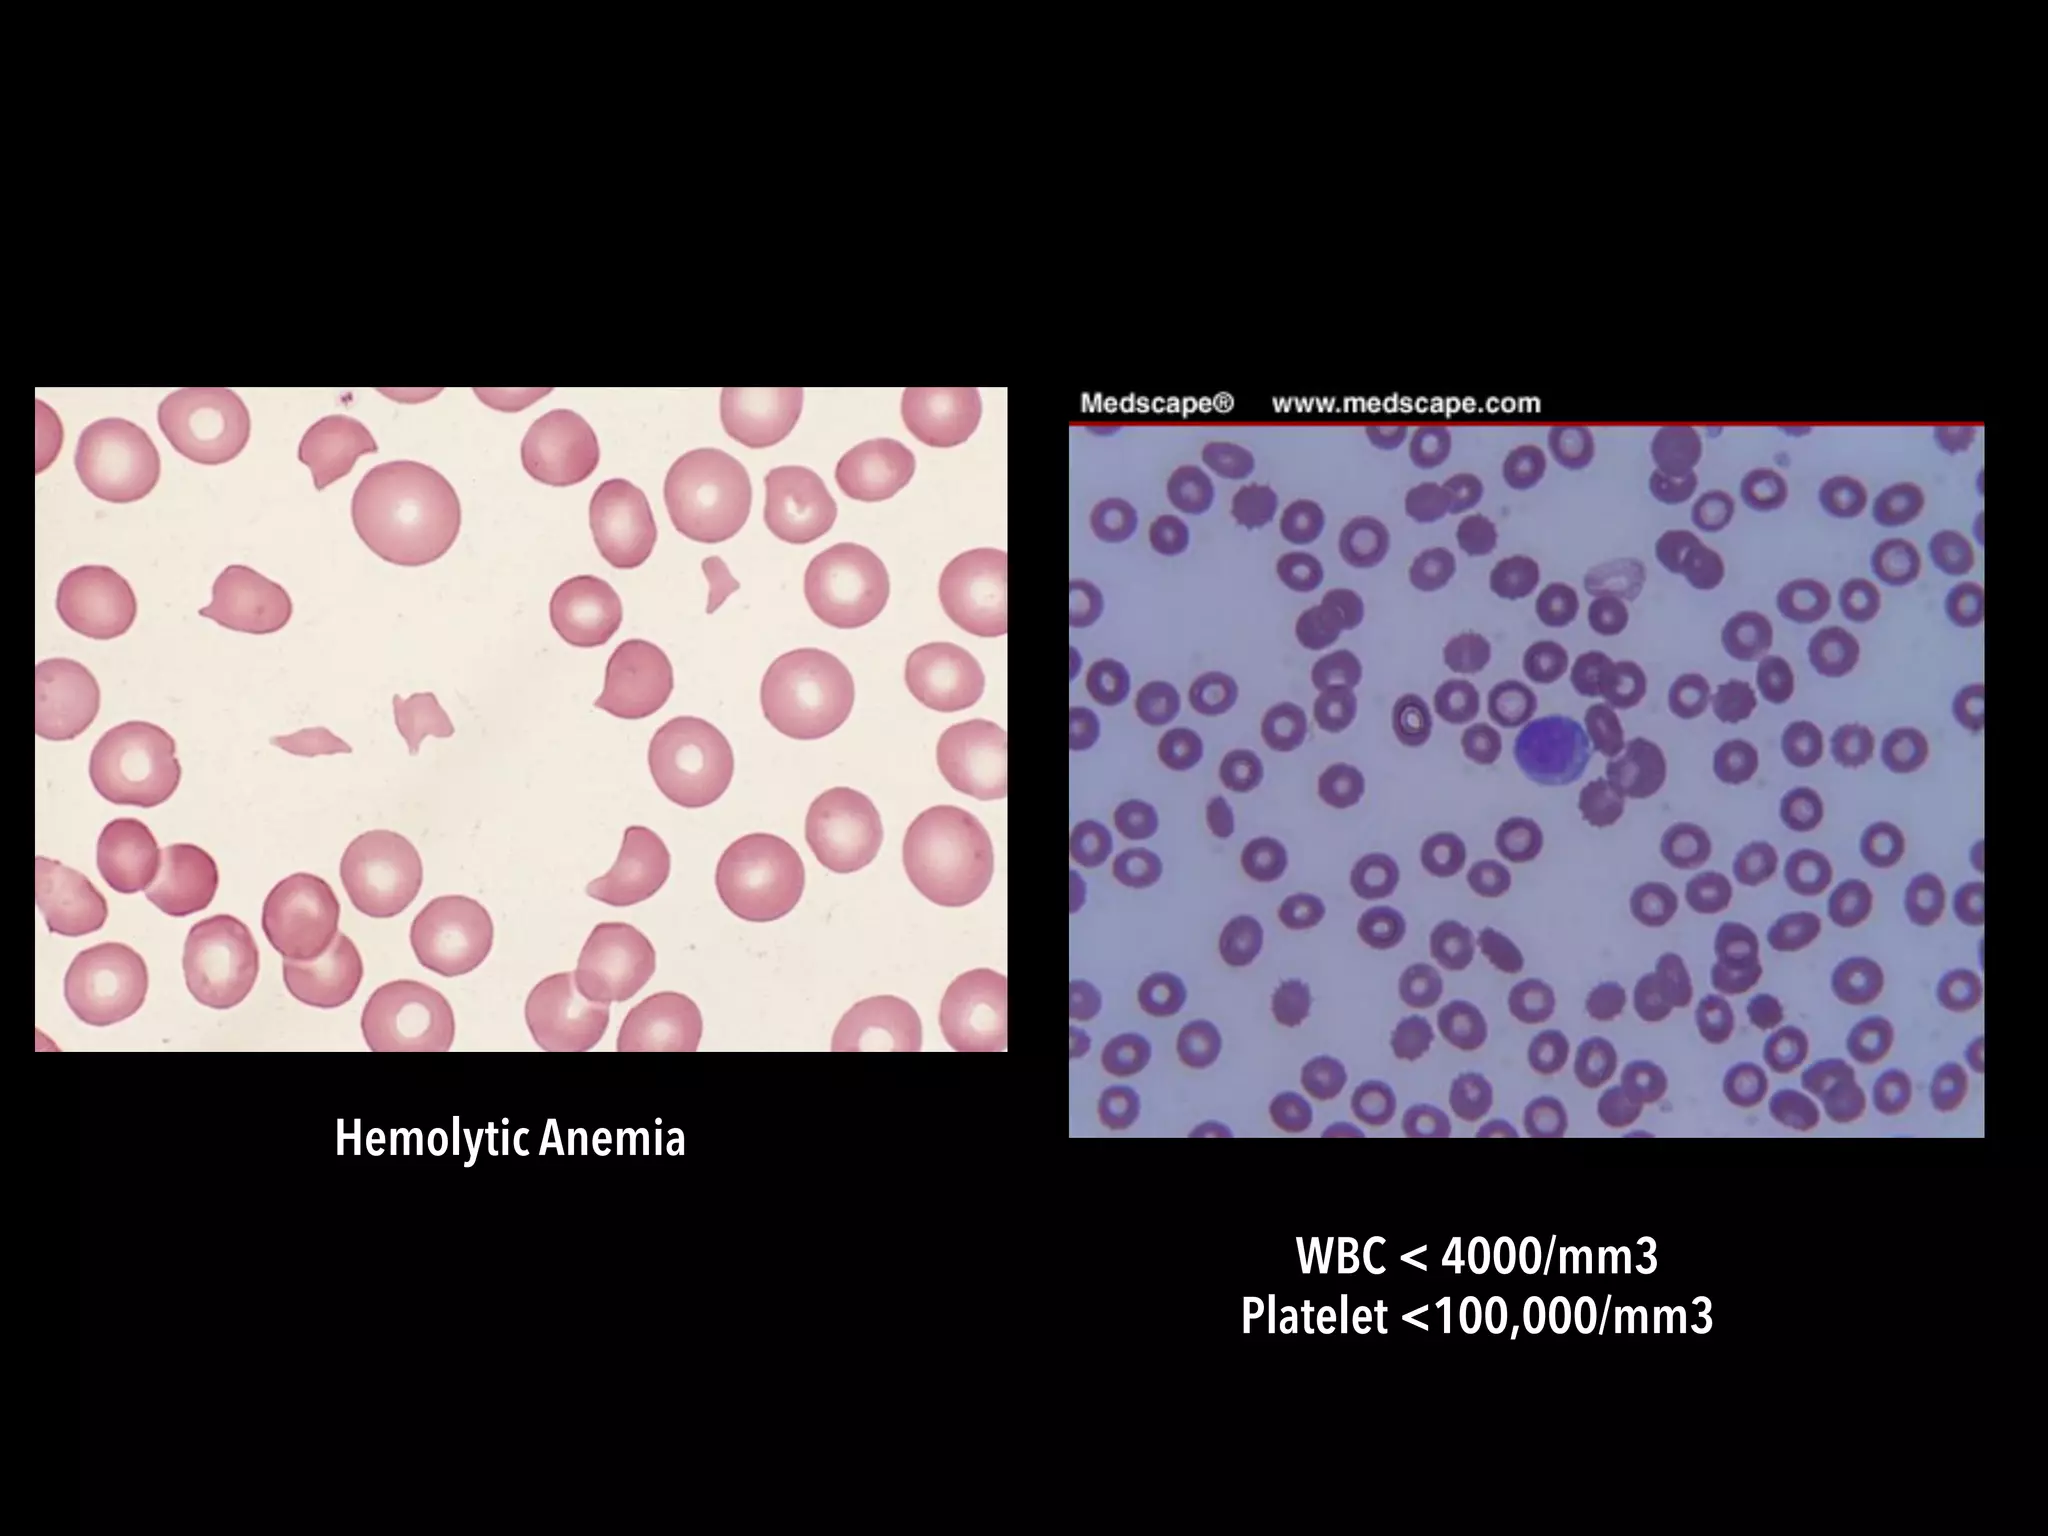
WBC < 4000/mm3
Platelet <100,000/mm3
Hemolytic Anemia

Lupus is a systemic autoimmune disease characterized by chronic inflammation that can affect multiple organs. It can cause a variety of symptoms affecting the skin, joints, kidneys, and other body systems. While there is no single diagnostic test, a combination of clinical features, lab tests like ANA, and organ involvement can help diagnose lupus. If left untreated, lupus can significantly impair quality of life, but treatment aims to control symptoms and prevent organ damage.